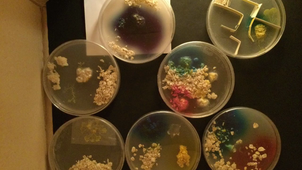

193 Chaînes
- CFA AGRICOLE DU LOIRET9 vidéos
- Collège ALAIN FOURNIER (36) VALENCAY19 vidéos
- Collège ALBERT CAMUS (18) VIERZON21 vidéos
- Collège ALPHONSE KARR (41) MONDOUBLEAU126 vidéos
- Collège BLOIS-BEGON (41) BLOIS15 vidéos
- Collège BLOIS-VIENNE (41) BLOIS15 vidéos
- Collège DE LA FORET (45) TRAINOU13 vidéos
- Collège EDOUARD HERRIOT (28) LUCE25 vidéos
- Collège GASTON HUET (37) VOUVRAY3 vidéos
- Collège GASTON JOLLET (41) SALBRIS15 vidéos
- Collège GEORGE SAND (18) AVORD2 vidéos
- Collège GEORGES BESSE (37) LOCHES10 vidéos
- Collège JEAN MONNET (28) LUISANT2 vidéos
- Collège JEAN MOULIN (45) ARTENAY6 vidéos
- Collège JEAN ZAY (37) CHINON10 vidéos
- Collège JULES VERNE (18) BOURGES10 vidéos
- Collège LE REFLESSOIR (37) BLERE20 vidéos
- Collège LES PROVINCES (41) BLOIS12 vidéos
- Collège LOUIS BLERIOT (28) TOURY16 vidéos
- Collège LOUIS PASTEUR (41) MOREE7 vidéos
- Collège MARCEL CARNE (41) VINEUIL23 vidéos
- Collège MICHEL CHASLES (28) EPERNON15 vidéos
- Collège MICHELET (37) TOURS3 vidéos
- Collège MONTABUZARD (45) INGRE7 vidéos
- Collège MONTAIGNE (37) TOURS5 vidéos
- Collège MONTJOIE (45) SARAN2 vidéos
- Collège SAINT-EXUPERY (18) BOURGES81 vidéos
- Collège VICTOR HUGO (18) BOURGES56 vidéos
 CONSEIL DEPARTEMENTAL DU LOIRET11 vidéos
CONSEIL DEPARTEMENTAL DU LOIRET11 vidéos- DRAAF Centre16 vidéos
 ENT15 vidéos
ENT15 vidéos GIP-RECIA2 vidéos
GIP-RECIA2 vidéos- ITS TOURS2 vidéos
- LEGTA DE CHÂTEAUROUX1 vidéo
- LEGTA DE VENDÔME2 vidéos
- LPA DE BEAUNE LA ROLANDE1 vidéo
- LPA DE MONTOIRE2 vidéos
- Lycée AUGUSTIN THIERRY (41) BLOIS30 vidéos
- Lycée BALZAC (37) TOURS1 vidéo
- Lycée BERNARD PALISSY (45) GIEN133 vidéos
- Lycée CAMILLE CLAUDEL (41) BLOIS3 vidéos
- Lycée CHARLES PEGUY (45) ORLEANS5 vidéos
- Lycée CHOISEUL (37) TOURS3 vidéos
- Lycée DESCARTES (37) TOURS3 vidéos
- Lycée DURZY (45) VILLEMANDEUR3 vidéos
- Lycée EDOUARD BRANLY (28) DREUX2 vidéos
- Lycée ELSA TRIOLET (28) LUCE1 vidéo
- Lycée EN FORET (45) MONTARGIS87 vidéos
- Lycée FICTIF LEN (45) OLIVET2 vidéos
- Lycée FRANCOIS VILLON (45) BEAUGENCY13 vidéos
- Lycée FULBERT (28) CHARTRES7 vidéos
- Lycée GRANDMONT (37) TOURS28 vidéos
- Lycée HENRI BRISSON (18) VIERZON4 vidéos
- LYCEE HORTICOLE DE BLOIS9 vidéos
- Lycée JACQUES COEUR (18) BOURGES8 vidéos
- Lycée JEAN DE BERRY (18) BOURGES58 vidéos
- Lycée JEAN ZAY (45) ORLEANS15 vidéos
- Lycée JEHAN DE BEAUCE (28) CHARTRES15 vidéos
- Lycée JOSEPH CUGNOT (37) CHINON4 vidéos
- Lycée MARCEAU (28) CHARTRES7 vidéos
- Lycée PASTEUR (36) LE BLANC4 vidéos
- Lycée POTHIER (45) ORLEANS5 vidéos
- Lycée ROTROU (28) DREUX15 vidéos
- Lycée SILVIA MONFORT (28) LUISANT14 vidéos
- Lycée SONIA DELAUNAY (41) BLOIS25 vidéos
- Lycée VOLTAIRE (45) ORLEANS2 vidéos
 Région Centre10 vidéos
Région Centre10 vidéos